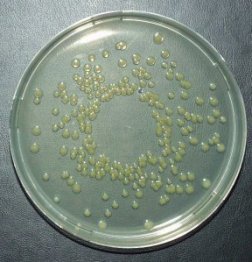

Formula for Failure
- More than 2 years ago
A bacterium that has been known to cause rare, yet fatal infections in infants appears to be more widespread than scientists have realized.
Enterobacter sakazakii has been implicated in only 60 reported cases of severe infection worldwide, mostly in premature babies and infants with immune systems weakened by illness. The result can be meningitis, an inflammation of the nervous system, or septicemia, bacterial poisoning of the blood—with mortality rates as high as 80 percent. In less-vulnerable babies, infections don’t seem to cause harm.
Studies have found the bacterium in sausage, spoiled tofu, minced beef, cheese, and vegetables. Other research has suggested, however, that infant formulas made from powdered milk were the source of E. sakazakii in at least four small outbreaks. Scientists say the formula could have gotten contaminated either during factory production or when babies’ caregivers prepared bottles for feedings. Indeed, studies have shown that E. sakazakii can survive in blenders used to mix baby formula in hospitals, and that the bacteria were present in about 20 of 141 cans of dry infant formula tested in 35 different countries.
Martine W. Reij, a food microbiologist at Wageningen University in the Netherlands, and her colleagues have been trying to learn where E. sakazakii enters formula on its way from a production line to a baby’s bottle. The bacteria are known to tolerate extremely dry conditions, and that describes most formula-production sites, Reij says.
The researchers decided to look for E. sakazakii in nine food factories and 16 households in Europe. After collecting multiple samples of floor sweepings and vacuum cleaner contents at the factories and vacuum cleaner bags from the households, the researchers put 10 grams of each dust sample in growth media that would indicate E. sakazakii‘s presence.
The investigators found the bacterium in all four powdered-milk factories examined, as well as plants making primarily chocolate, cereal, potato flour, and pasta. E. sakazakii was found in 9 percent up to 44 percent of the samples from each of these sites. Five of the 16 households also had E. sakazakii. The only food factory where the bacteria were not present was a spice factory. “We found it almost everywhere,” says Reij. The report appears in the Jan. 3 Lancet.
Reij points out that her group’s study found that E. sakazakii is widespread but didn’t confirm that the bacterium got into commercial baby formula. “We don’t know whether it reaches the product and whether it’ll grow to dangerous concentrations,” Reij explains.
In a commentary accompanying the new report, Jeffrey M. Farber, director of the Bureau of Microbial Hazards for the Food Directorate of Health Canada, says E. sakazakii deserves more study: “Although E. sakazakii does not appear to be as important a pathogen as others that have emerged in the past, the fact that the disease it causes has a very high mortality rate and that the organism affects very young infants is a cause for concern.”







